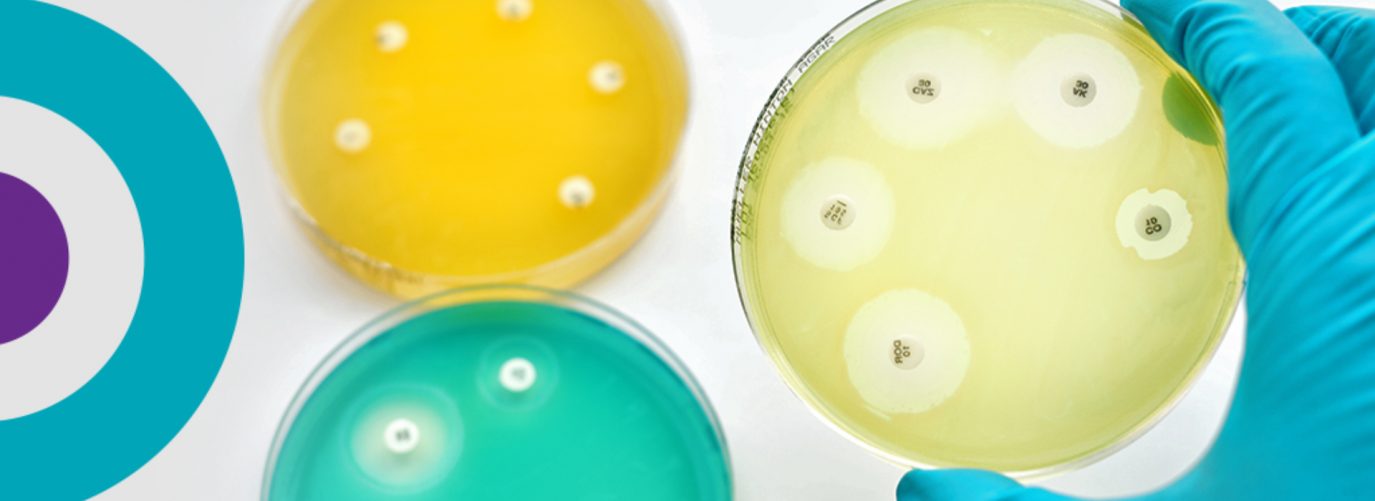
petri dishes showing antimicrobial resistance

Antimicrobial resistance: is it too late to suppress the superbugs?
16 November 2017
World Antibiotic Awareness Week is spreading the message that we all have a role to play in fighting antimicrobial resistance.
Imagine we have travelled through time, to a world where there are no organ transplants, no joint replacements, and no cosmetic surgical procedures. Even in the world’s richest countries, maternal and infant mortality rates skyrocket, and common infections claim thousands of lives every year.
You might assume that we’re in the past, before scientific endeavour brought about the medical procedures and treatments we now take for granted. But unfortunately not. This is, potentially, the future – a bleak world in which antimicrobial resistance has nullified many of healthcare’s pivotal achievements.
What is antimicrobial resistance?
Antimicrobial resistance occurs when microorganisms, such as bacteria, mutate and become resistant to antimicrobial drugs, such as antibiotics. Although it’s a natural evolutionary process, it is hugely accelerated through misuse of these drugs. But you didn’t need me to tell you that – you’ve heard all about it already. In fact, we’ve known about resistance to antibiotics for almost as long as we’ve known about antibiotics themselves. In 1945, having just won a Nobel Prize for the discovery of penicillin, Alexander Fleming warned that it was ‘not difficult to make microbes resistant to penicillin in the laboratory’ and that ‘the same thing [had] happened in the body’. He correctly predicted that inappropriate use of antibiotics might lead to the spread of resistance among bacteria. But even Fleming probably didn’t foresee quite how inappropriate our use of antibiotics would become.

Antibiotics were once hailed as a ‘miracle cure’. As with most miracles, this was too good to be true.
Misuse of a miracle
Antibiotics were once hailed as a ‘miracle cure’. As with most miracles, this was too good to be true. Excessive use of the drugs has hindered their effectiveness. In 2015, Nature reported that global antibiotic consumption grew by 30% between 2000 and 2010. Despite awareness of antimicrobial resistance, particularly concerning antibiotics, clinicians continue to prescribe these drugs even when they’re not needed. Sore throats, for example, are usually viral infections; only 10% will respond to antibiotics, and yet antibiotics are prescribed in as many as 60% of cases. The US Centers for Disease Control and Prevention (CDC) has reported that at least 30% of antibiotics prescribed in the US are unnecessary.
Overprescription has contributed to a rise in antibiotic resistance. As a BBC report points out: ‘Bacterial resistance is essentially a numbers game: the more humans try to kill bacteria with antibiotics, and the more different antibiotics they use, the more opportunities bacteria have to develop new genes to resist those antibiotics.’
Underuse is another part of the problem. In some countries, poor access to antimicrobial treatments may force patients to use substandard alternatives or take an incomplete course. While there is debate over whether antibiotics must be taken as an entire course, there is evidence that exposure to suboptimal doses makes bacteria more likely to develop resistance. To paraphrase Friedrich Nietzsche: what doesn’t kill you makes you stronger.
Of course, antibiotic use is not limited to healthcare. A huge culprit in the misuse of these drugs is the agriculture industry, where they have been used not only to prevent infection but also to promote animal growth. Although the EU banned antibiotics as growth promoters 10 years ago, other countries continue this practice. The US Food and Drug Administration only removed growth from the indicated uses on drug labelling in 2017. In China, around 15,000 tons of antibiotics were used in livestock in 2010, and the country’s antibiotic consumption is projected to double by 2030.
The rise of antimicrobial resistance is compounded by the dearth of new drugs. Owing partly to a lack of incentives, research and development is slow; only two new antibiotic classes have been introduced in the past 40 years. Given the speed with which bacteria can develop resistance, it’s not hard to see why we are losing the arms race.
What would a world without antimicrobials look like?
The dystopia to which I alluded at the start of this post – and which forms the setting of a recent science-fiction comic book series – may seem extreme, but the reality is that we are hugely dependent on antimicrobial drugs. Antibiotics are essential for infection prevention in surgery, so it is likely that minor operations would be considered too risky without them. Additionally, anyone with a suppressed immune system – owing to chronic illness, cancer treatment, organ transplants or any other reason – could be at risk of death even from minor infections.
And it’s not just antibiotics. Antiviral medications are also coming up against resistance. There have been reports from various countries of drug-resistant influenza, malaria and HIV. This is a global problem, requiring a global solution – and time is running out.
How can we combat antimicrobial resistance?
Without buy-in from all stakeholders, we can’t realistically expect to win the fight against antimicrobial resistance. The World Health Organization is using this year’s World Antibiotic Awareness Week (13–19 November) to raise awareness of what we can all do to combat the crisis. Any solution must be viewed as a continuum, including infection prevention, incentives for research and development, improved surveillance and diagnostics, alternative treatments and widespread behaviour change. As emphasised in an editorial in The Lancet Global Health, everyone has a role to play, including patients, researchers, healthcare providers, farmers, veterinarians, the media and policymakers.
Only by taking responsibility for our part in this problem, and acting accordingly to solve it, will we see a brighter future. Let’s do all we can to ensure that the dystopian vision of a world without antimicrobials retains its rightful place – in fiction, not reality.


